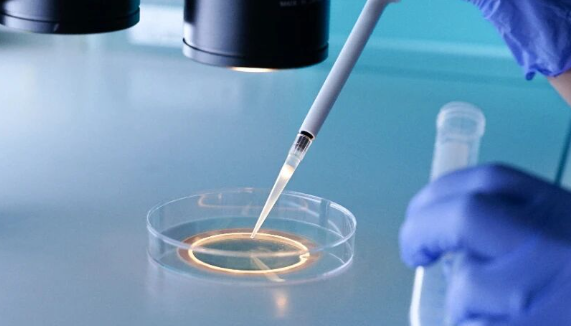

吉尔吉斯斯坦私立医院做试管婴儿承诺包成功是否靠谱?吉尔吉斯斯坦私立医院承诺试管婴儿包成功通常不靠谱,属于夸大宣传。试管婴儿的成功率受多种因素影响,目前没有任何一家医院能够保证100%成功。试管婴儿技术为许多不孕不育夫妇带来了生育的希望,但选择医院和了解相关信息至关重要,切勿盲目相信“包成功”的承诺。
一、试管婴儿成功率的影响因素
试管婴儿的成功率是一个复杂的问题,受到诸多因素的影响,没有任何医疗机构可以完全掌控这些因素,并做出“包成功”的保证。以下是影响试管婴儿成功率的一些主要因素:
1.女性年龄
女性的年龄是影响试管婴儿成功率的最重要因素之一。随着女性年龄的增长,卵巢功能逐渐衰退,卵子数量和质量都会下降。35岁以后,卵子的染色体异常率明显升高,导致胚胎质量下降,从而降低试管婴儿的成功率。例如,25-30岁的女性,试管婴儿的单次成功率可能达到60%-70%,而40岁以上的女性,成功率可能仅有20%-30%。
2.卵巢功能
卵巢功能直接影响着卵子的数量和质量。卵巢储备功能下降的女性,可能需要更大的促排卵药物剂量才能获得足够的卵子,而且获得的卵子质量也可能较差。一些疾病,如多囊卵巢综合征(PCOS)和卵巢早衰(POF)也会影响卵巢功能,进而影响试管婴儿的成功率。
3.精子质量
精子的质量同样重要。精子数量不足、活力低下或形态异常都会影响受精和胚胎发育。一些男性因素,如无精症、少精症和弱精症,可能需要通过睾丸取精等技术来获取精子,并进行单精子卵胞浆内注射(ICSI)辅助受精。
4.胚胎质量
胚胎的质量是决定试管婴儿成功与否的关键因素。高质量的胚胎具有更高的着床和发育潜能。胚胎的质量受到卵子和精子的质量、受精方式以及实验室培养环境等多种因素的影响。胚胎移植前遗传学筛查(PGS)或胚胎移植前遗传学诊断(PGD)可以帮助选择染色体正常的胚胎进行移植,从而提高成功率。
5.子宫内膜环境
子宫内膜是胚胎着床的场所。子宫内膜的厚度、形态和血流供应都会影响胚胎的着床。一些子宫疾病,如子宫内膜异位症、子宫肌瘤和子宫内膜炎,可能会影响子宫内膜的容受性,降低试管婴儿的成功率。
6.医疗技术水平
医院的医疗技术水平和医生的经验对试管婴儿的成功率至关重要。经验丰富的医生能够根据患者的具体情况制定个性化的治疗方案,并熟练掌握促排卵、取卵、胚胎培养和移植等技术。先进的实验室设备和严格的质量控制体系也能够提高胚胎的培养质量。
二、吉尔吉斯斯坦私立医院的试管婴儿现状
吉尔吉斯斯坦的医疗水平相对发展中国家而言可能存在一定差距。私立医院虽然在服务和环境上可能优于公立医院,但在技术水平、设备和医生经验方面可能良莠不齐。因此,在选择吉尔吉斯斯坦的私立医院进行试管婴儿时,需要格外谨慎。
1.资质认证
选择医院时,首先要确认医院是否具有合法的执业资质,是否获得了吉尔吉斯斯坦卫生部门的批准,可以开展辅助生殖技术。可以通过官方网站或咨询当地卫生部门来查询医院的资质信息。
2.医生经验
了解医生的专业背景、从业经验和成功案例。选择经验丰富的医生可以提高试管婴儿的成功率。可以咨询医院或通过网络搜索来了解医生的信息。
3.技术设备
了解医院的实验室设备和技术水平。先进的实验室设备和严格的质量控制体系可以提高胚胎的培养质量。可以参观医院或咨询医院的工作人员来了解相关信息。
4.成功率数据
谨慎对待医院提供的成功率数据。一些医院可能会夸大成功率来吸引患者。可以要求医院提供详细的成功率数据,并与其他医院的数据进行比较。同时,要了解成功率的计算方法和影响因素。
三、“包成功”承诺的风险
任何一家医院承诺“包成功”都是不负责任的。试管婴儿的成功率受到多种因素的影响,没有任何医疗机构可以完全掌控这些因素。一些医院为了吸引患者,可能会夸大成功率,甚至做出“包成功”的承诺。这种承诺往往隐藏着风险:
1.隐形消费
一些医院可能会以“包成功”为诱饵,吸引患者签订合同。但在治疗过程中,可能会以各种理由增加费用,导致患者花费超出预期。
2.虚假宣传
一些医院可能会夸大成功率,甚至提供虚假的成功案例。患者在选择医院时,要保持警惕,不要轻信虚假宣传。
3.医疗风险
为了提高成功率,一些医院可能会过度使用促排卵药物,增加患者的医疗风险。例如,卵巢过度刺激综合征(OHSS)是一种常见的促排卵并发症,严重时可能危及生命。
四、试管婴儿的合理预期
试管婴儿并非万能,患者应该对试管婴儿的成功率有一个合理的预期。在选择医院和医生时,要充分了解相关信息,并根据自身情况制定个性化的治疗方案。同时,要保持积极的心态,配合医生的治疗,才能提高试管婴儿的成功率。
以下是一些建议:
选择正规、有资质的医院。
选择经验丰富的医生。
充分了解试管婴儿的流程和风险。
保持积极的心态,配合医生的治疗。
不要轻信“包成功”的承诺。
*图文内容仅供学习参考,不能作为诊断依据,个体有差异,如有不适请前往正规医院就诊!

上海
重庆
北京
天津